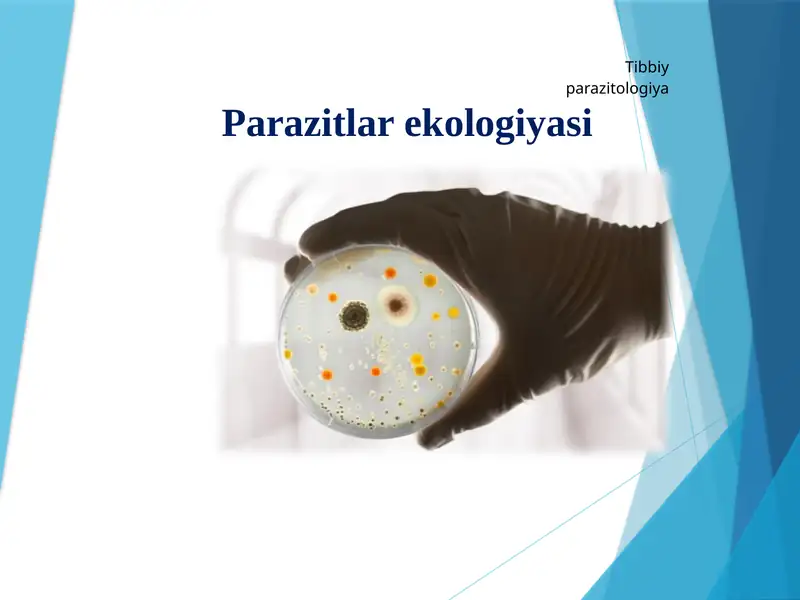
card img

Barcha mahsulotlar
TaqdimotlarKurs ishlariMustaqil ishlarDiplom ishlariBlankalarBiznes rejalarElektron kitoblarStatistikaMaqolaPlakatlarLoyihalarIjodiy IshlarAmaliy ishlarDasturlash tillariNamunaviy hujjatlarO'quv qo'llanmalarTarqatma materiallarDars ishlanmalarTestlarReferatlarIxtiro patentiDissertatsiya ishlariLabaratoriya Ishlari
.pptx

MUHANDISLIK GEOLOGIYASI VA GRUNTLAR MEXANIKASI
4 500 so’m
.pptx

Chiqindilarni boshqarish
6 600 so’m
.pptx

O‘lkadagi rekratsiya resurslari
4 000 so’m
.pptx

Ekologik siyosatning tuzilmasi va asosiy bosqichlari
4 000 so’m
.pptx

Barqaror turizm va yashil mehmonxonalar global tendensiyalar
5 500 so’m
.pptx

Mehmonxonalar va ekologik amaliyotlar: chiqindilarni boshqarish
5 500 so’m
.ppt

Талаб ва таклиф эластиклиги
6 100 so’m
.pptx

Dengiz ekosistemasi. Hamjamiyat va ekosistema
5 800 so’m
.ppt

Экология в современном мире
6 000 so’m
.pptx

Ekologiya Masalalari Kasalliklarni Oldini Olish
9 000 so’m
.pptx

UYUSHMA, EKOSISTEMA VA BIOSFERANING BIOFIZIK ASOSLARI
10 000 so’m
.pptx

Arganik va kimyo atrof muhitini ximoya qilish
4 500 so’m
.pptx

Eng yaxshi ekologik loyiha
4 500 so’m
.pptx

Tabiiy fanlarda tabiatni muhofaza qilishga doir OʻQUV loyihasi metodikasi Taqdimot (slayd)
4 500 so’m
.pptx

Suv resurslaring kamayishi va ifloslanishi
4 500 so’m
.pptx

Global climate change
4 500 so’m
.pptx

Develop your individual action plan to solving environmental issues
4 500 so’m
.pptx

Tog'-kon, kimyo va metallurgiya sanoati hamda atrof-muhit muhofazasi
5 500 so’m
.pptx

Global problems of the present
4 500 so’m
.pptx

Global ekologik mamolar
3 000 so’m
.pptx

Qishloq xо‘jalik ekinlari zararkunandalariga qarshi qо‘llaniladigan insektitsid, akaritsidlar va ularning qо‘llanilishi
4 000 so’m
.pptx

Parniklar tavsifi
4 000 so’m
.pptx

Qishloq xoʻjaligi sanoatida ventilyatsiyasining qoʻllanishi haqida maʼlumotlar bilan tanishish
4 000 so’m
.pptx

Orol fojiasi
4 000 so’m
.pptx

Non-conventional renewable energy sources
4 000 so’m
.pptx

Natural Disasters and Extreme Weather Events
4 500 so’m
.pptx

Les Problèmes Écologiques
4 500 so’m
.pptx

Aziq-awqat mashqalasin shishiwdin ilimiy tiykarlari
4 500 so’m
.pptx

Atrof-muhitni muxofaza qilishning ilmiy asoslari
4 500 so’m
.pptx

Davlat ekologik nazorati
4 500 so’m
.pptx

Ekologiya tiykarlari
4 000 so’m
.pptx

Globallashuv va ekalogik xafsizlik
6 100 so’m
.pptx

Maxsus muhofaza qilinadigan tabiiy hududlar va ularning ekologik iqtisodiy muammolari
4 000 so’m
.pptx
Parazitlar ekologiyasi
4 800 so’m
.pptx

Flower Petals
4 000 so’m
.pptx

Yashil iqtisodiyot”ga o‘tishning zaruriyati, tamoyillari va dastaklari.
4 800 so’m
.pptx

Water Pollution
10 000 so’m
.pptx

Deforestation
10 000 so’m
.pptx

Ekologik omillar va madaniyat
3 700 so’m
.pptx

TVM-25V
3 500 so’m
.pptx

Energetika va atrof-muhit
3 500 so’m
.pptx

Tabiat bilan tanishtirish metodikasida ta'limiy o'yinlar
3 500 so’m
.pptx

Tuproqlarni mulchalash
3 500 so’m
.pptx

Climate Change Presentation
4 000 so’m
.pptx

Okean Resurslaridan Foydalanish
4 000 so’m
.pptx

Natur
4 000 so’m
.pptx

My Living Place
4 000 so’m
.pptx

O'zaro bog'langan Internet
4 000 so’m
.pptx

Manzarali Daraxtlar
4 000 so’m
.pptx

Landshaft Tashkil Qiluvchi Omillar Va Landshaftning Tarkibiy Qismlari
4 000 so’m
Tayyor mahsulotlardan foydalanish qanday ishlaydi?

Qidiring va tanlang
Katalogdan yoki qidiruv orqali sizga kerakli tayyor mahsulotni toping.

Sotib oling
Xavfsiz to‘lov tizimi orqali mahsulotni sotib oling — narx va shartlar oldindan ko‘rinadi.

Yuklab oling va foydalaning
Mahsulotni darhol yuklab oling va ishlatishni boshlang.
SOFF
SOFF
Kerakli mahsulotni topa olmadingizmi? Buyurtma berishingiz mumkin.
Bizning mutaxassislarimiz sizga yordam berishga tayyor
Buyurtmar berish